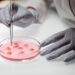
Ζήτημα δημόσιας υγείας η μικροβιακή αντοχή σε βακτήρια που μεταδίδονται μέσω τροφίμων

Μία σπάνια τηλεοπτική συνέντευξη έδωσε η Άννα Μπιθικώτση και αναφέρθηκε στη σχέση της με τους γονείς της. Η κόρη του Γρηγόρη Μπιθικώτση μίλησε για εκείνον και για την παρουσία του την οποία στερήθηκε από τη στιγμή που έγινε διάσημος.
Παράλληλα, η Άννα Μπιθικώτση, που ήταν καλεσμένη στο πλατό της εκπομπής «Καλύτερα αργά» ήταν το βράδυ της Τετάρτης (19.02.2026) αναφέρθηκε στα δύσκολα χρόνια που είχε βιώσει ο Γρηγόρης Μπιθικώστης, ενώ μίλησε και για τους θανάτους των γονιών της.
«Ήταν προστατευτικός. Τα μάτια του είχαν δει πολλά. Ήταν σκληρά χρόνια, αλλά ήταν και γλυκά χρόνια», ανέφερε αρχικά η Άννα Μπιθικώτση για τον πατέρα της, Γρηγόρη Μπιθικώτση.
Η Άννα Μπιθικώτση είπε στη συνέχεια: «Έχω κρατήσει τις αναμνήσεις από τότε που είχα τον πατέρα μου, πριν μου τον πάρει ο κόσμος. Το τίμημα της δόξας για εμάς, τα παιδιά των μύθων, είναι αυτό. Για να τον έχει ο κόσμος, τον στερούμαστε εμείς. Δεν κάναμε Χριστούγεννα ή διακοπές μαζί, επικοινωνούσαμε με ραβασάκια και ποιήματα που του γράφαμε. Το είχα συνηθίσει. Αυτή ήταν η ζωή μας. Δεν ήταν θυμός, ήταν μια γλυκιά πίκρα».
Η Άννα Μπιθικώτση πρόσθεσε επίσης: «Ευτυχώς υπήρχε η μαμά. Η μοδίστρα που γνώρισε στα 19 της και αγάπησε τον άσημο Γρηγόρη και έμεινε μαζί του 30 χρόνια. Η μαμά ήταν η ισορροπία μας. Αν δεν υπήρχε, ίσως να μην είχαμε διαμορφώσει αυτόν τον χαρακτήρα εγώ και η αδερφή μου. Ο μπαμπάς μας έκανε όλα τα χατίρια, ειδικά σε μένα που μου είχε αδυναμία».
Αναφερόμενη στο χωρισμό των γονιών της, η Άννα Μπιθικώτση είπε: «Θα απαντήσω με έναν στίχο που έγραψε η μητέρα μου. “Ο έρωτας γεννήθηκε για δύο και τρίτος δεν χωράει μες στους δύο”. Οπότε τα είπαμε όλα. Δεν χώρισαν στην ουσία ποτέ. Μέχρι την τελευταία του πνοή ο πατέρας αγαπούσε τη μητέρα μου και μέχρι την τελευταία της πνοή η μητέρα μιλούσε για τον Γρηγόρη. Κρατούσε τα κοστούμια και τις γραβάτες του, γυάλιζε τα παπούτσια του σαν να περίμενε να γυρίσει».
Κλείνοντας, η Άννα Μπιθικώτση είπε: «Με το ίδιο μαντήλι που σκούπισα το δάκρυ του πατέρα μου πριν φύγει από τη ζωή, άγγιξα και τα δάκρυα της μητέρας μου πριν πεθάνει».